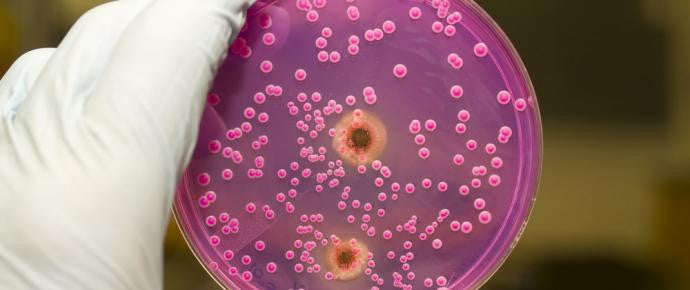

5 easy ways to banish yeast infections!

Although most people believe that a yeast infection is a bacterial infection – it's actually a FUNGAL infection. The fungus responsible for yeast infections is called Candida albicans. This occurs naturally in the body and usually stays in check, but when the body is out of balance or the immune system is run down, Candida can be quite nasty and "overgrow" into a virulent fungal state that causes a systemic infection. Yeast infections most commonly take hold in the vagina or mouth (thrush), groin (jock itch), or feet (athlete's foot) but can occur anywhere in the body too. It is caused by an imbalance which in turn causes the yeast to run rampant.
1. GARLIC + CRANBERRY
Eat more fresh garlic added to meals and drink cranberry juice or eat them as dry fruit. Cranberries actually help to reduce the PH in the bladder and in turn in urine, helping to 'wash' the vaginal area clean. Garlic has been vastly studied for its natural powerful ability to fight fungus!
2. A LEMON A DAY…
As fungal infections often begin when there is an imbalance of PH, lemons have long been known to help the body restore PH balance (try drinking lemon in water if you suffer from heartburn and you'll see what a difference it makes to your stomach!). Lemon juice can be added to bath water to address external skin fungal infections too! Lemons also help the immune system stay strong – making it an all round superhero for yeast infections!
3. PLAIN YOGHURT
Recommended by health care professionals for years, plain un-sweetened yoghurt (preferably organic) contains Lactobacillus acidophilus. This is naturally occurring HEALTHY bacteria that help to fight fungal infection. Eat yoghurt to restore healthy bacteria to the gut. Apply a small amount topically on the vulva for several nights (to aid thrush), washing clean each day with water and a clean dry cloth (no soap). Coat the mouth if you suffer from oral thrush.
4. MILD VINEGAR
A quick home remedy is a MILD vinegar solution. Mix 1 tablespoon of vinegar or apple cider vinegar with 1 litre of water. Use this solution to soak your feet (athlete's foot) or hands (nail fungus). You can also use it as a wash to splash out the vaginal (thrush) or mouth (oral thrush).
5. DON’T STAY WET …
The best friend of fungal infection is wet, warm conditions which causes it to multiply! To banish fungal infection, stay DRY and make sure the area is aerated. Wear loose-fitting underwear (or if you can go under-wear-free until the infection clears). Change immediately out of wet swimming gear or sweat-soaked gym clothes. Out of respect for others, make sure you don’t share bath or swimming towels at home. Always notify your sexual partner of any fungal infection of the genitals.
The natural fight against yeast: remember that commercial soaps, lotions, creams and some sexual lubricants can disturb normal vaginal PH and leave you at risk for yeast infection. Rather invest in natural products to stop itching and natural gels to keep the PH of the vagina in balance. A good systemic detox is also a measure that can be taken to guard against Candida infection. If you are run down make sure that you support your immune system and follow a healthy diet. We have a special free Candida diet guide, request it from us here: help@feelgoodhealth.co.za


Comments
Leave a comment